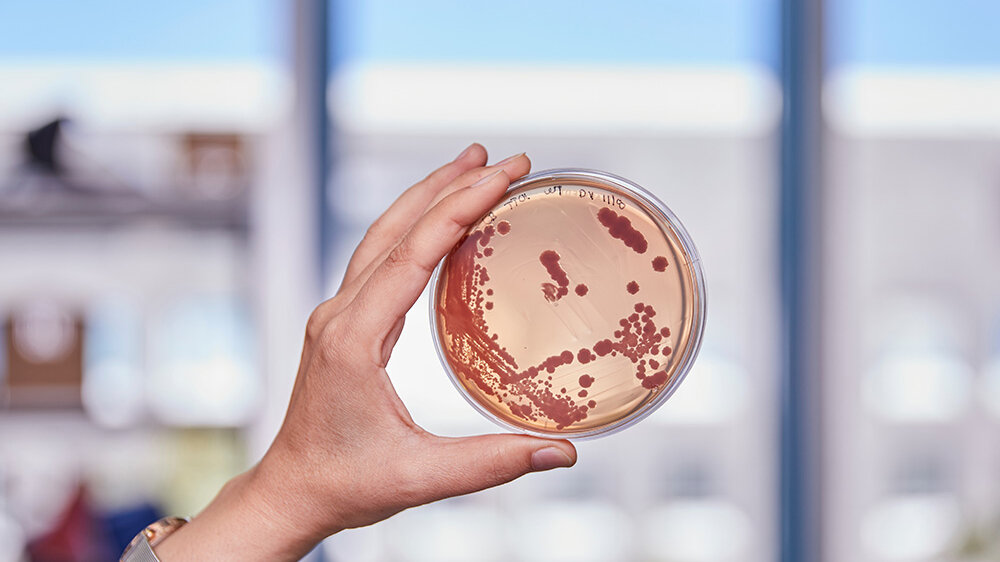
Bakterienkultur

Nicht der Mensch hat das Fließbandprinzip erfunden. Bakterien verschaffen sich mit diesem Prinzip einen Vorteil, um in den unterschiedlichsten Lebensräumen zu bestehen: Nicht-ribosomale Peptid-Synthetasen (NRPS) bilden eine enorme Vielfalt an Naturstoffen nach dem Baukastenprinzip. NRPS sind bakterielle Enzyme, die unterschiedliche Bausteine binden, aktivieren oder verknüpfen kann. Die Vielfalt entsteht hier nicht durch die Menge an Bausteinen, sondern den Aufbau der NRPS selbst, durch die Kombination ihrer Enzym-Untereinheiten.
Natur als Vorbild
Viele unserer Medikamente, wie Antibiotika oder Krebsmedikamente, sind durch diese Enzymkomplexe entstanden. Das Forschungsteam um Prof. Dr. Helge Bode am Max-Planck-Institut für terrestrische Mikrobiologie in Marburg arbeitet daran, dieses Enzymsystem gezielt für die Produktion neuer Wirkstoffe zu nutzen. Doch bisher funktioniert es nicht wie erhofft. „Wir sehen eine große Chance darin, von der Natur zu lernen. Wenn wir die natürlichen Prozesse verstehen, wissen wir, welche Bereiche des Enzyms sich am besten für das NRPS-Engineering eignen“, erklärt Dr. Kenan Bozhüyük, einer der Erstautoren der aktuellen Studie.
Die Forschenden widmeten sich daher der Frage, welche Untereinheiten besonders gut zusammenarbeiten. Sie untersuchten, wo die Evolution selbst eingreift und neue Fließbänder erstehen für neue, notwendige Naturstoffe. Um „Hotspots“ der natürlichen Rekombination zu finden, analysierten die Forschenden zehntausend Enzyme. In Laborexperimenten überprüften sie anschließend vorhergesagte Zielstellen und fanden so einen Hotspot für die gezielte Herstellung funktionsfähiger NRPS-Hybride.
Fusionspunkt der NRPS
So konnte die Forschungsgruppe NRPS-Sequenzen aus komplett unterschiedlichen Organismen wie Bakterien und Pilzen zusammenführen. Der letzte Meilenstein war die Überprüfung in einem klinischen Setting. Mithilfe des „Fusionspunktes“ bauten die Forschenden ein neues, pharmakologisch aktives Peptid: der Beweis für das große Potenzial der Naturstoffe als Basis zur Entwicklung neuer Medikamente.
„Im Bereich der synthetischen Biologie und der evolutionären Biochemie hat die Forschung in den letzten Jahren enorme Fortschritte gemacht,“ so Bode. „Der Vorteil unseres Ansatzes ist, dass wir evolutionäre Prozesse nutzen, die sich über Millionen von Jahren bewährt haben. Unsere von der Evolution inspirierten Fusionsstellen sind vielseitiger und haben höhere Erfolgsraten.“ Durch die Verbindung der synthetischen Biologie und Hochdurchsatzmethoden möchten die Forschenden künftig maßgeschneiderte biologische Arzneimittel entwickeln – mit verbesserten therapeutischen Eigenschaften. Aufgrund der steigenden Arzneimittelresistenzen und Wirkstoff-Unverträglichkeiten ist dies ein wichtiges Unterfangen.
Quelle: idw
Artikel teilen